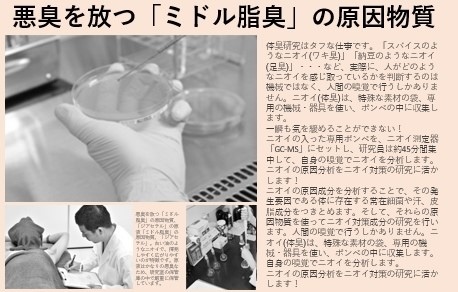

2.0大升級!!!日本紅來台灣!!!天然系除臭皂,無味+美白+去痘的完美軽肌皂,連SAM老師都大推👍
日本內分泌權威醫師發現 ,人體的皮脂原本不會造成臭味,但是一旦汗水和角質接觸到空氣,被細菌和微生物分解後,就會就會氧化變成2-壬烯醛(2-Nonenal)產生臭味。隨著年齡增加,累積的角質越多,體味就會越來越濃厚。

最近剛好看到日本熱夯的 『解決體味新對策』, 居然出了升級版!!!!!!
天然素材 消除的體味根源 話題(感覺好厲害呀 … )

這個季節如果不想要身上有臭味怎麼辦啊?你也有這個困擾嗎?身上若能持續無味又清香,面對人群也自在多了~
目標

日本大阪醫學會研發 天然柿子萃取 ,以天然成分達到 長時間 持續根源消味 + 嫩白 + 控油 3 效合一 ,運用日本DX 分解系統。深層清潔多餘油脂與毛孔髒污,分解細菌抑制生長,達到深層除臭消味,搭配2.0最新配方, 日日夜夜都清新。

來自大阪為出汗身體異味所開發,幫體味做全方位的管理與潔淨,打造清爽無味 無荳潔白的體味對策,連保養專家SAM老師都讚不絕口的說『使用一個禮拜後,出門都不用擔心異味了』!

(翻攝自日本MAX新聞特別報導)
這是日本厚生省認證的專業及
升級配方
,成分天然而且全身上下,男女老少都可使用,只要洗完澡就有 長時間消味效果,難怪在日本掀起熱烈討論,連新聞都特別報導
小編找到了最優惠的組合,快點來看看~優惠別錯過!

做事嚴謹的日本人要上巿前,總是要經過完整 無菌無臭的 測試, 編編自己用了也是超感動的 ~

(翻攝自日本大前研究社 もう臭わない 洗後長時間無菌實驗報告)
因為優越的抗菌系統,聽說連背痘都可輕鬆消除(難怪在意形象的日本人少不了它

黑皂在日本造成大轟動,獨特的 智能緩釋 因子 ( インテリジェントなダイナミック ) 能深入清潔,分解抑菌,控油白嫩 ,聽說日本人氣運動員維持運動後無臭和皮膚光滑的清新形象就是靠它

3大天然嚴選+Atsushi DX小分子高酵素配方,而且還是日本厚生省認可,能有效全天候除臭,成分全日本製造無添加,使用更安心
日本和歌山縣柿渋液:深入毛孔根源分解+抑菌,老化角質紀州職人備長炭:溶解吸走異味、抑制油垢分泌,疏通毛孔丹波條山黑豆: 促進皮膚細胞代謝,消除黑斑、青春痘,同步嫩白

2.0 升級版新添加了更優質的成分,讓肌膚達到更加完美的肌膚狀態。
【銀精華】:內含白金奈米微粒,具抗氧化效果,肌膚因老化的皺紋、青春痘以及白頭粉刺,等引起的肌膚乾燥狀況,有緩解作用。
【玉米澱粉】:可溶性微粒的玉米澱粉,能夠藉由按摩,達到溫和去除肌膚老廢角質的美肌效果。

體臭、加齡臭、幼童汗臭都可以用天然的軽肌皂來保持全天候無味唷~

2.0升級版的黑皂真的洗得好乾淨,升級配方讓肌膚更光滑更美肌!

從日本來台上巿前也邀請台灣美麗達人阿米,來確認台灣人的膚質及環境適用度! ( 日本人就是龜毛嚴謹呀 ) 讓我們看看美麗達人的測試報告 >>
日本原裝品質令人期待~特別的日式和風黑皂, 流線型設計好掌握不會溜來溜去!

假日剛好要出門,前一天馬上用黑皂洗澡!

用起來很好起泡,清新的味道,男女都適合,洗完肌膚很細嫩,還能維持持時間強效無味,出門雖然有流一些汗,回家仔細聞,身體完全沒有味道!(長時間發揮效用的DX 分解系統果然厲害!

也幫我家的臭小子洗,隔天放學身上真的沒味道了!我們家臭小孩有救了(不得不佩服日本人的專業

男女都適合,洗完肌膚好細嫩,優質商品別錯過唷~

而且我家老公連續洗了一周,連困擾他多年的背痘也好超多了!根本一舉兩得!(太感動了)

現在每天晚上都用黑皂洗澡,出門即使流汗也不擔心有怪味~不用噴香水掩蓋臭臭,直接利用日 本 DX 分解系統來分解汗水細菌!!炎炎夏日好乾爽,也可以放心穿上美麗的大露背心真的好開心 !

1987年成立於日本大阪,在日本醫美封閉通路低調研發30年,只供醫師與名媛貴婦使用,產品致力於專業醫美級訴求,天然元素便可達到卓越效果,因此使用智慧與淨美的「淳Atsushi」作為品牌名稱。

日本厚生省認證專業級配方,天然成分讓使用者得到最佳呵護與安心,天然醫美級護膚新商品在日本上市後,受到專業人士喜愛,在封閉通路常造成搶貨熱潮。

男女都適合,洗完肌膚好細嫩,優質商品別錯過唷~

最近剛好看到日本熱夯的 『解決體味新對策』, 居然出了升級版!!!!!!

這個季節如果不想要身上有臭味怎麼辦啊?你也有這個困擾嗎?身上若能持續無味又清香,面對人群也自在多了~
目標
日本大阪醫學會研發 天然柿子萃取 ,以天然成分達到 長時間 持續根源消味 + 嫩白 + 控油 3 效合一 ,運用日本DX 分解系統。深層清潔多餘油脂與毛孔髒污,分解細菌抑制生長,達到深層除臭消味,搭配2.0最新配方, 日日夜夜都清新。

來自大阪為出汗身體異味所開發,幫體味做全方位的管理與潔淨,打造清爽無味 無荳潔白的體味對策,連保養專家SAM老師都讚不絕口的說『使用一個禮拜後,出門都不用擔心異味了』!

(翻攝自日本MAX新聞特別報導)
這是日本厚生省認證的專業及
小編找到了最優惠的組合,快點來看看~優惠別錯過!

做事嚴謹的日本人要上巿前,總是要經過完整 無菌無臭的 測試, 編編自己用了也是超感動的 ~

(翻攝自日本大前研究社 もう臭わない 洗後長時間無菌實驗報告)
因為優越的抗菌系統,聽說連背痘都可輕鬆消除(難怪在意形象的日本人少不了它

黑皂在日本造成大轟動,獨特的 智能緩釋 因子 ( インテリジェントなダイナミック ) 能深入清潔,分解抑菌,控油白嫩 ,聽說日本人氣運動員維持運動後無臭和皮膚光滑的清新形象就是靠它

3大天然嚴選+Atsushi DX小分子高酵素配方,而且還是日本厚生省認可,能有效全天候除臭,成分全日本製造無添加,使用更安心
日本和歌山縣柿渋液:深入毛孔根源分解+抑菌,老化角質紀州職人備長炭:溶解吸走異味、抑制油垢分泌,疏通毛孔丹波條山黑豆: 促進皮膚細胞代謝,消除黑斑、青春痘,同步嫩白

【銀精華】:內含白金奈米微粒,具抗氧化效果,肌膚因老化的皺紋、青春痘以及白頭粉刺,等引起的肌膚乾燥狀況,有緩解作用。
【玉米澱粉】:可溶性微粒的玉米澱粉,能夠藉由按摩,達到溫和去除肌膚老廢角質的美肌效果。

體臭、加齡臭、幼童汗臭都可以用天然的軽肌皂來保持全天候無味唷~

2.0升級版的黑皂真的洗得好乾淨,升級配方讓肌膚更光滑更美肌!

從日本來台上巿前也邀請台灣美麗達人阿米,來確認台灣人的膚質及環境適用度! ( 日本人就是龜毛嚴謹呀 ) 讓我們看看美麗達人的測試報告 >>
日本原裝品質令人期待~特別的日式和風黑皂, 流線型設計好掌握不會溜來溜去!

假日剛好要出門,前一天馬上用黑皂洗澡!

用起來很好起泡,清新的味道,男女都適合,洗完肌膚很細嫩,還能維持持時間強效無味,出門雖然有流一些汗,回家仔細聞,身體完全沒有味道!(長時間發揮效用的DX 分解系統果然厲害!

也幫我家的臭小子洗,隔天放學身上真的沒味道了!我們家臭小孩有救了(不得不佩服日本人的專業

男女都適合,洗完肌膚好細嫩,優質商品別錯過唷~

而且我家老公連續洗了一周,連困擾他多年的背痘也好超多了!根本一舉兩得!(太感動了)

現在每天晚上都用黑皂洗澡,出門即使流汗也不擔心有怪味~不用噴香水掩蓋臭臭,直接利用日 本 DX 分解系統來分解汗水細菌!!炎炎夏日好乾爽,也可以放心穿上美麗的大露背心真的好開心 !

1987年成立於日本大阪,在日本醫美封閉通路低調研發30年,只供醫師與名媛貴婦使用,產品致力於專業醫美級訴求,天然元素便可達到卓越效果,因此使用智慧與淨美的「淳Atsushi」作為品牌名稱。

日本厚生省認證專業級配方,天然成分讓使用者得到最佳呵護與安心,天然醫美級護膚新商品在日本上市後,受到專業人士喜愛,在封閉通路常造成搶貨熱潮。

男女都適合,洗完肌膚好細嫩,優質商品別錯過唷~
